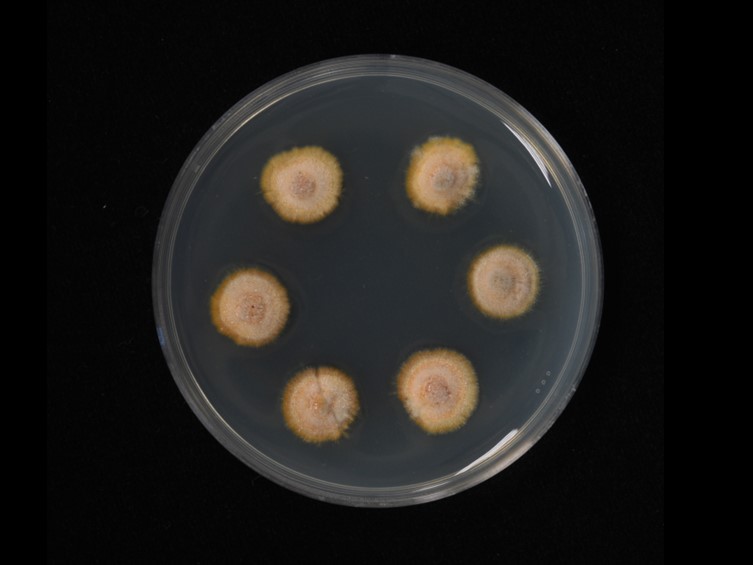

Holotype:
THAILAND, Nakhon Si Thammarat Province, Khao Luang Naional Park, 18 Feb. 2009, A. Khonsanit, S. Mongkolsamrit, R. Promharn, P. Srikitikulchai, K. Tasanathai, holotype BBH 27004, ex-type living culture BCC 36100.
Habitat:
Underside of dicotyledonous leaves.
Host:
Armored scale insect (Diaspididae).
Description:
 Stromata planar, pulvinate, pale yellow, orange to reddish brown, 3-5 mm in diam.
Stromata planar, pulvinate, pale yellow, orange to reddish brown, 3-5 mm in diam.  Perithecia usually present on a slight weft of hyphae, scattered or clustered, usually 2-5 (rarely 12), ovoid, 220-420 μm long, 100-180 μm wide.
Perithecia usually present on a slight weft of hyphae, scattered or clustered, usually 2-5 (rarely 12), ovoid, 220-420 μm long, 100-180 μm wide.  Asci 8-spored, cylindrical, 160-180 × 5-7.5 μm, with cap approx. 3 μm thick.
Asci 8-spored, cylindrical, 160-180 × 5-7.5 μm, with cap approx. 3 μm thick.  Ascospores whole, aseptate, 80-150 × 1.5-2.5 μm, cylindrical, tapering at distal ends.
Ascospores whole, aseptate, 80-150 × 1.5-2.5 μm, cylindrical, tapering at distal ends.
Culture characteristics:
Colonies on PDA attaining 10 mm diam after 4 wk, white at first, turning grayish orange with age. Colonies formed a compact felt-like mycelium. Hirsutella-like asexual state arises from hyphae, conidiogenous structures with slender base tapering more or less evenly to a neck, 30–40 × 1–2 mm, hyaline, produced directly on prostrate hyphae on the margin of the stromatic colonies from ca 4 wk on wards. Conidia hyaline, smooth, fusiform and slightly curved, 3–4 transverse septa, produced singly or two at the neck apex, sometimes in mucous sheath, 8–15 × 2–4 mm.
Colonies on PDA attaining 10 mm diam after 4 wk, white at first, turning grayish orange with age. Colonies formed a compact felt-like mycelium. Hirsutella-like asexual state arises from hyphae, conidiogenous structures with slender base tapering more or less evenly to a neck, 30–40 × 1–2 mm, hyaline, produced directly on prostrate hyphae on the margin of the stromatic colonies from ca 4 wk on wards. Conidia hyaline, smooth, fusiform and slightly curved, 3–4 transverse septa, produced singly or two at the neck apex, sometimes in mucous sheath, 8–15 × 2–4 mm.
Reference:
Mongkolsamrit S, Thanakitpipattana D, Khonsanit A, et al. (2016). Conoideocrella krungchingensis sp. nov., an entomopathogenic fungus from Thailand. Mycoscience 57 : 264–270.
DOI: https://doi.org/10.1016/j.myc.2016.03.003Species |
Strain |
Compound |
Pubchem CID |
Biological activity |
Reference |
|---|
|
Strain |
LSU | TEF1 |
|---|---|---|
| BCC 36100 | KJ435080 | KJ435097 |
| BCC 36101 | KJ435081 | KJ435098 |
| BCC 53666 | KJ435070 | KJ435099 |
| BCC 53667 | KJ435071 | KJ435100 |